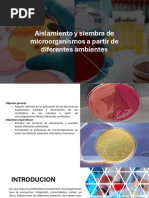

0% encontró este documento útil (0 votos)
46 vistas10 páginasTécnicas de Siembra Microbiana
La siembra microbiana es el procedimiento para depositar microorganismos en medios de cultivo. Existen varias técnicas de siembra como en tubos o placas petri, incluyendo por enjuague, estrias, puntura o gotero. La siembra en profundidad usa muestras previamente diluidas y placas con medio sólido licuado.
Cargado por
bilder rojas rivadeneiroDerechos de autor
© © All Rights Reserved
Nos tomamos en serio los derechos de los contenidos. Si sospechas que se trata de tu contenido, reclámalo aquí.
Formatos disponibles
Descarga como PDF, TXT o lee en línea desde Scribd
0% encontró este documento útil (0 votos)
46 vistas10 páginasTécnicas de Siembra Microbiana
La siembra microbiana es el procedimiento para depositar microorganismos en medios de cultivo. Existen varias técnicas de siembra como en tubos o placas petri, incluyendo por enjuague, estrias, puntura o gotero. La siembra en profundidad usa muestras previamente diluidas y placas con medio sólido licuado.
Cargado por
bilder rojas rivadeneiroDerechos de autor
© © All Rights Reserved
Nos tomamos en serio los derechos de los contenidos. Si sospechas que se trata de tu contenido, reclámalo aquí.
Formatos disponibles
Descarga como PDF, TXT o lee en línea desde Scribd